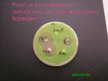
Prezentācija 'Antibiotikas un rezistence pret tām', 18.

-
Antibiotikas un rezistence pret tām

-
Antibiotikas un rezistence pret tām
VidusskolaPrezentācija25 -
Tonsilīts
VidusskolaPrezentācija30 -
Trīs baktēriju izraisītas saslimšanas
VidusskolaPrezentācija15
Antibiotikas un rezistence pret tām
Faila izmērs:
25264 KB
Identifikators:
1382122